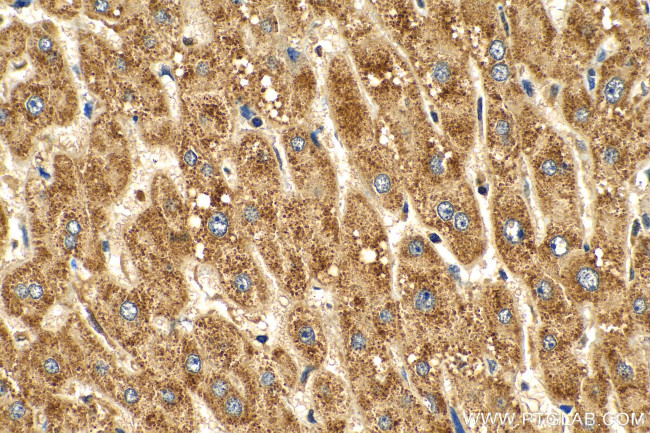
KLHL28 Antibody in Immunohistochemistry (Paraffin) (IHC (P))
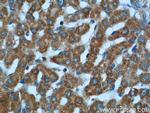
KLHL28 Antibody in Immunohistochemistry (Paraffin) (IHC (P))
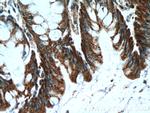
KLHL28 Antibody in Immunohistochemistry (Paraffin) (IHC (P))
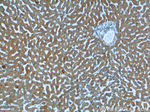
KLHL28 Antibody in Immunohistochemistry (Paraffin) (IHC (P))

Search
Proteintech
KLHL28 Polyclonal Antibody
{{$productOrderCtrl.translations['antibody.pdp.commerceCard.promotion.promotions']}}
{{$productOrderCtrl.translations['antibody.pdp.commerceCard.promotion.viewpromo']}}
{{$productOrderCtrl.translations['antibody.pdp.commerceCard.promotion.promocode']}}: {{promo.promoCode}} {{promo.promoTitle}} {{promo.promoDescription}}. {{$productOrderCtrl.translations['antibody.pdp.commerceCard.promotion.learnmore']}}
产品信息
25224-1-AP
种属反应
宿主/亚型
分类
类型
抗原
偶联物
形式
浓度
规格
纯化类型
保存液
内含物
保存条件
运输条件
产品详细信息
Immunogen sequence: NSVRLPLLS VKFLTRLYEA NHLIRDDRTC KHLLNEALKY HFMPEHRLSH QTVLMTRPRC APKVLCAVGG KSGLFACLDS VEMYFPQNDS WIGLAPLNIP RYEFGICVLD QKVYVIGGIA TNVRPGVTIR KHENSVECWN PDTNTWTSLE RMNESRSTLG VVVLAGELYA LGGYDGQSYL QSVEKYIPKI RKWQPVAPMT TTRSCFAAAV LDGMIYAIGG YGPAHMNSVE RYDPSKDSWE MVASMADKRI HFGVGVMLGF IFVVGGHNGV SHLSSIERYD PHQNQWTVCR PMKEPRTGVG AAVIDNYLYV VGGHSGSSYL NTVQKYDPIS DTWLDSAGMI YCRCNFGLTA L (222-571 aa encoded by BC121009)
靶标信息
BTBD5 is a transcription factor containing BTB (POZ) domain.
仅用于科研。不用于诊断过程。未经明确授权不得转售。
篇参考文献 (0)
生物信息学
蛋白别名: BTB (POZ) domain containing 5; BTB/POZ domain-containing protein 5; kelch-like 28; Kelch-like protein 28; unnamed protein product
基因别名: 2810440N09Rik; 4122402F11Rik; 4931401E10Rik; BTBD5; KLHL28
UniProt ID: (Human) Q9NXS3, (Mouse) Q9CR40
Entrez Gene ID: (Human) 54813, (Mouse) 66689